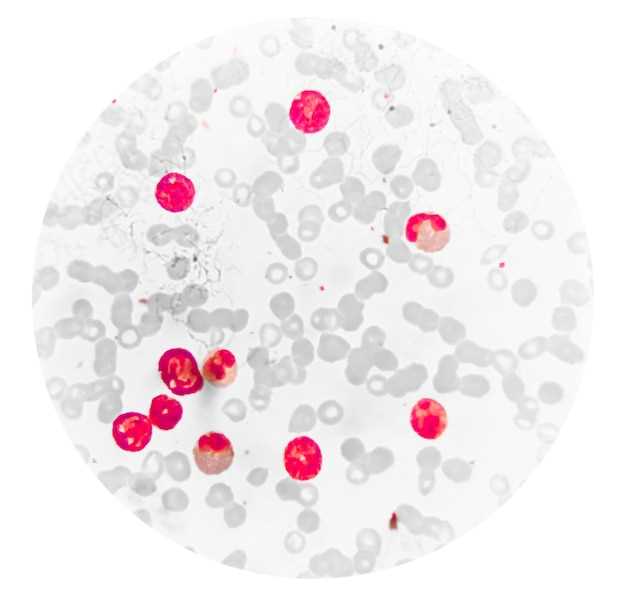
undefinedDiscover the benefits and potential side effects of low-dose Seroquel and how it can improve your mental health.</em>

Lage dosis seroquel
2026-02-06Seroquel is an effective medication used to treat certain mental or mood disorders, such as schizophrenia and bipolar disorder. It contains an active ingredient called quetiapine that helps regulate the levels of certain chemicals in the brain. When taken in low doses, Seroquel can be a beneficial option for individuals experiencing mild symptoms or seeking a maintenance therapy.

Discover the benefits and potential side effects of low-dose Seroquel and how it can improve your mental health.